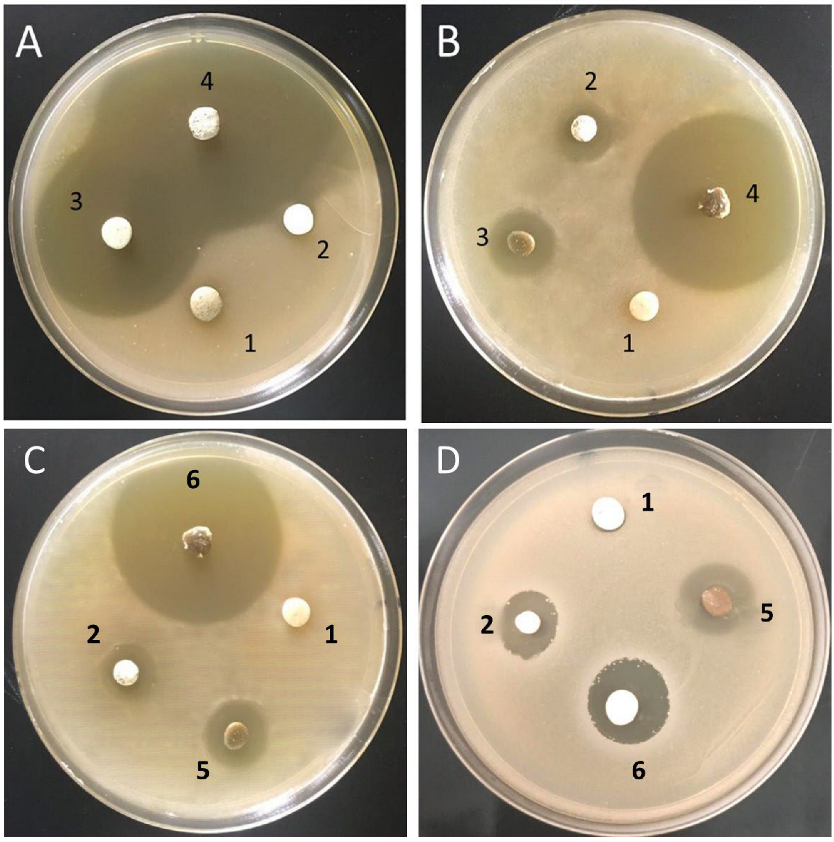
Antibiotics 11 00756 g007 Antibiotics 11 00756 g007

Comparison and Advanced Antimicrobial Strategies of Silver and Copper Nanodrug-Loaded Glass Ionomer Cement against Dental Caries Microbes
Abstract
1. Introduction
2. Materials and Methods
2.1. Experimental Design
2.2. Materials and Equipment
2.3. Biosynthesis of Copper Nanoparticles
2.3.1. TVE-CuNP Characterization
UV-Visible Spectrum
Transmission Electron Microscopy (TEM)
X-ray Diffraction
Fourier Transform Infrared Analysis (FT-IR)
2.4. Preparation and Characterization of AgNPs
2.5. Preparation of Specimens
- (Group 1) GIC.
- (Group 2) GIC and 1.5% metronidazole.
- (Group 3) 99.5% GIC with 0.5% TVE-CuNPs.
- (Group 4) 98% GIC with 0.5% TVE-CuNPs and 1.5% metronidazole.
- (Group 5) 99.5% GIC with 0.5% AgNPs.
- (Group 6) 98% GIC with 0.5% AgNPs and 1.5% metronidazole.
2.6. Drug Release Determination
2.7. Bacteria and Growth Conditions
2.7.1. Amicrobial Efficacy Using Agar Disc Diffusion Assay
2.7.2. Modified Direct Contact Test
2.8. Compressive Strength Measurement
2.9. Statistical Analysis
3. Results
3.1. Biosynthesis of TVE-CuNPs
3.2. Characterization of TVE-CuNPs
3.2.1. UV-Vis Spectroscopy of TVE-CuNPs
3.2.2. Size and Shape of TVE-CuNPs
3.2.3. X-ray Diffraction (XRD)
3.2.4. Comparison of FTIR Spectra of Thymus vulgaris Extract and TVE-CuNPs
3.3. Characterization of AgNPs
3.4. Drug Release Determination
3.5. Antimicrobial Activity of the Tested Biomaterials
3.6. Compressive Strength Measurement
4. Discussion
5. Conclusions
Author Contributions
Funding
Institutional Review Board Statement
Informed Consent Statement
Data Availability Statement
Acknowledgments
Conflicts of Interest
Sample Availability
References
- Naik, R.G.; Dodamani, A.S.; Khairnar, M.R.; Jadhav, H.C.; Deshmukh, M.A. Comparative assessment of antibacterial activity of different glass ionomer cements on cariogenic bacteria. Restor. Dent. Endod. 2016, 41, 278–282. [Google Scholar] [CrossRef]
- Wang, S.P.; Ge, Y.; Zhou, X.D.; Xu, H.H.; Weir, M.D.; Zhang, K.K.; Wang, H.H.; Hannig, M.; Rupf, S.; Li, Q.; et al. Effect of anti-biofilm glass-ionomer cement on Streptococcus mutans biofilms. Int. J. Oral Sci. 2016, 8, 76–83. [Google Scholar] [CrossRef] [PubMed]
- Horowitz, A.M. Introduction to the symposium on minimal intervention techniques for caries. J. Public Health Dent. 1996, 56, 133–134; discussion 161–163. [Google Scholar] [CrossRef] [PubMed]
- Liu, Y.; Ren, Y.; Li, Y.; Su, L.; Zhang, Y.; Huang, F.; Liu, J.; Liu, J.; van Kooten, T.G.; An, Y.; et al. Nanocarriers with conjugated antimicrobials to eradicate pathogenic biofilms evaluated in murine in vivo and human ex vivo infection models. Acta Biomater. 2018, 79, 331–343. [Google Scholar] [CrossRef] [PubMed]
- Allaker, R.P.; Yuan, Z. Nanoparticles and the control of oral biofilms. Nanobiomaterials Clin. Dent. 2019, 243–275. [Google Scholar]
- Gutierrez, M.F.; Alegria-Acevedo, L.F.; Mendez-Bauer, L.; Bermudez, J.; Davila-Sanchez, A.; Buvinic, S.; Hernandez-Moya, N.; Reis, A.; Loguercio, A.D.; Farago, P.V.; et al. Biological, mechanical and adhesive properties of universal adhesives containing zinc and copper nanoparticles. J. Dent. 2019, 82, 45–55. [Google Scholar] [CrossRef]
- Xu, V.W.; Nizami, M.Z.I.; Yin, I.X.; Yu, O.Y.; Lung, C.Y.K.; Chu, C.H. Application of copper nanoparticles in dentistry. Nanomaterials 2022, 12, 805. [Google Scholar] [CrossRef]
- Almuhaiza, M. Glass-ionomer Cements in Restorative Dentistry: A Critical Appraisal. J. Contemp. Dent. 2016, 17, 331–336. [Google Scholar] [CrossRef]
- Bollu, I.P.; Hari, A.; Thumu, J.; Velagula, L.D.; Bolla, N.; Varri, S.; Kasaraneni, S.; Nalli, S.V. Comparative Evaluation of Microleakage Between Nano-Ionomer, Giomer and Resin Modified Glass Ionomer Cement in Class V Cavities- CLSM Study. J. Clin. Diagn. Res. 2016, 10, ZC66–ZC70. [Google Scholar] [CrossRef]
- Slavin, Y.N.; Asnis, J.; Häfeli, U.O.; Bach, H. Metal Nanoparticles: Understanding the Mechanisms behind Antibacterial Activity. J. Nanobiotechnol. 2017, 15, 65. [Google Scholar] [CrossRef]
- Wang, Y.W.; Tang, H.; Wu, D.; Liu, D.; Liu, Y.; Cao, A.; Wang, H. Enhanced Bactericidal Toxicity of Silver Nanoparticles by the Antibiotic Gentamicin. Environ. Sci. Nano 2016, 3, 788–798. [Google Scholar] [CrossRef]
- Castilho, A.R.F.; Duque, C.; Kreling, P.F.; Pereira, J.A.; Paula, A.B.; Sinhoreti, M.A.C.; Puppin-Rontani, R.M. Doxycycline-containing glass ionomer cement for arresting residual caries: An in vitro study and a pilot trial. J. Appl. Oral Sci. 2018, 26, e20170116. [Google Scholar] [CrossRef] [PubMed]
- Mitchell, D.A. Metronidazole: Its use in clinical dentistry. J. Clin. Periodontol. 1984, 11, 145–158. [Google Scholar] [CrossRef]
- Smith, A. Metronidazole resistance: A hidden epidemic? Br. Dent. J. 2018, 224, 403–404. [Google Scholar] [CrossRef] [PubMed]
- Gad El-Rab, S.M.F.; Basha, S.; Ashour, A.A.; Enan, E.T.; Alyamani, A.A.; Felemban, N.H. Green Synthesis of Copper Nano-Drug and Its Dental Application upon Periodontal Disease-Causing Microorganisms. J. Microbiol. Biotechnol. 2021, 31, 1656–1666. [Google Scholar] [CrossRef]
- Abolghasemi, R.; Haghighi, M.; Solgi, M.; Mobinikhaledi, A. Rapid synthesis of ZnO nanoparticles by waste thyme (Thymus vulgaris L.). Int. J. Environ. Sci. Technol. 2019, 16, 6985–6990. [Google Scholar] [CrossRef]
- Felemban, N.H.; Ebrahim, M.I. Effects of adding silica particles on certain properties of resin-modified glass ionomer cement. Eur. J. Dent. 2016, 10, 225–229. [Google Scholar] [CrossRef][Green Version]
- Enan, E.T.; Ashour, A.A.; Basha, S.; Felemban, N.H.; Gad El-Rab, S.M.F. Antimicrobial activity of biosynthesized silver nanoparticles, amoxicillin, and glass-ionomer cement against Streptococcus mutans and Staphylococcus aureus. Nanotechnology 2021, 32, 215101. [Google Scholar] [CrossRef]
- Hudzicki, J. Kirby-Bauer. Disk Diffusion Susceptibility Test Protocol; American Society of Microbiology: Washington, DC, USA, 2016. [Google Scholar]
- Lewinstein, I.; Matalon, S.; Slutzkey, S.; Weiss, E.I. Antibacterial properties of aged dental cements evaluated by direct contact and agar diffusion tests. J. Prosthet. Dent. 2005, 93, 364–371. [Google Scholar] [CrossRef]
- Chandraker, S.K.; Ghosh, M.K.; Lal, M.; Ghorai, T.K.; Shukla, R. Colorimetric sensing of Fe3+ and Hg2+ and photocatalytic activity of green synthesized silver nanoparticles from the leaf extract of Sonchus arvensis L. New J. Chem. 2019, 43, 18175–18183. [Google Scholar] [CrossRef]
- Mallick, K.; Witcomb, M.J.; Scurrell, M.S. In situ synthesis of copper nanoparticles and poly(o-toluidine): A metal–polymer composite material. Eur. Polym. J. 2006, 42, 670–675. [Google Scholar] [CrossRef]
- Adewale Akintelu, S.; Kolawole Oyebamiji, A.; Charles Olugbeko, S.; Felix Latona, D. Green chemistry approach towards the synthesis of copper nanoparticles and its potential applications as therapeutic agents and environmental control. Curr. Res. Green Sustain. Chem. 2021, 4, 100176. [Google Scholar] [CrossRef]
- Dutta, D.; Phukan, A.; Dutta, D.K. Nanoporous montmorillonite clay stabilized copper nanoparticles: Efficient and reusable catalyst for oxidation of alcohols. Mol. Catal. 2018, 451, 178–185. [Google Scholar] [CrossRef]
- Honarmand, M.; Golmohammadi, M.; Hafezi-bakhtiari, J. Synthesis and characterization of SnO2 NPs for photo-degradation of eriochrome black-T using response surface methodology. Environ. Sci. Pollut. Res. 2021, 28, 7123–7133. [Google Scholar] [CrossRef]
- Agnihotri, S.; Mukherji, S.; Mukherji, S. Size-Controlled Silver Nanoparticles Synthesized over the Range 5–100 Nm Using the Same Protocol and Their Antibacterial Efficacy. RSC Adv. 2014, 4, 3974–3983. [Google Scholar] [CrossRef]
- Paramelle, D.; Sadovoy, A.; Gorelik, S.; Free, P.; Hobley, J.; Fernig, D.G. A Rapid Method to Estimate the Concentration of Citrate Capped Silver Nanoparticles from UV-Visible Light Spectra. Analyst 2014, 139, 4855–4861. [Google Scholar] [CrossRef]
- Ma, Y.-W.; Wu, Z.-W.; Zhang, L.-H.; Zhang, J.; Jian, G.-S.; Pan, S. Theoretical Study of the Local Surface Plasmon Resonance Properties of Silver Nanosphere Clusters. Plasmonics 2013, 8, 1351–1360. [Google Scholar] [CrossRef]
- England, C.G.; Miller, M.C.; Kuttan, A.; Trent, J.O.; Frieboes, H.B. Release kinetics of paclitaxel and cisplatin from two and three layered gold nanoparticles. Eur. J. Pharm. Biopharm. 2015, 92, 120–129. [Google Scholar] [CrossRef] [PubMed]
- De Paula, A.; De Fúcio, S.; Alonso, R.; Ambrosano, G.; Puppin-Rontani, R. Influence of chemical degradation on the surface properties of nano restorative materials. Oper Dent. 2014, 39, E109–E117. [Google Scholar] [CrossRef]
- Mittal, S.; Soni, H.; Sharma, D.K.; Mittal, K.; Pathania, V.; Sharma, S. Comparative evaluation of the antibacterial and physical properties of conventional glass ionomer cement containing chlorhexidine and antibiotics. J. Int Soc. Prev. Community Dent. 2015, 5, 268–275. [Google Scholar] [CrossRef]
- Aguilar-Perez, D.; Vargas-Coronado, R.; Cervantes-Uc, J.M.; Rodriguez-Fuentes, N.; Aparicio, C.; Covarrubias, C.; Alvarez-Perez, M.; Garcia-Perez, V.; Martinez-Hernandez, M.; Cauich-Rodriguez, J.V. Antibacterial activity of a glass ionomer cement doped with copper nanoparticles. Dent. Mater. J. 2020, 39, 389–396. [Google Scholar] [CrossRef] [PubMed]
- Kaur, A.; Kumar, R. Enhanced bactericidal efficacy of polymer stabilized silver nanoparticles in conjugation with different classes of antibiotics. RSC Adv. 2019, 9, 1095–1105. [Google Scholar] [CrossRef]
- Zia, R.; Riaz, M.; Farooq, N.; Qamar, A.; Anjum, S. Antibacterial activity of Ag and Cu nanoparticles synthesized by chemical reduction method: A comparative analysis. MRE 2018, 5, 075012. [Google Scholar] [CrossRef]
- Gad El-Rab, S.M.F.; Ashour, A.A.; Basha, S.; Alyamani, A.A.; Felemban, N.H.; Enan, E.T. Well-Orientation Strategy Biosynthesis of Cefuroxime-Silver Nanoantibiotic for Reinforced Biodentine™ and Its Dental Application against Streptococcus mutans. Molecules 2021, 26, 6832. [Google Scholar] [CrossRef]
- Rahman, S.A.; Umashankar, G.K.; Selvan, A.; Sharma, R.; Maniyar, R.; Kavya, M.J. To evaluate the antimicrobial efficacy of conventional glass ionomer cement incorporated with different antibiotics: An in-vitro study. Int. J. Oral Health Med. Res. 2016, 3, 30–34. [Google Scholar]
- Ashour, A.A.; Basha, S.; Felemban, N.H.; Enan, E.T.; Alyamani, A.A.; Gad El-Rab, S.M.F. Antimicrobial Efficacy of Glass Ionomer Cement in Incorporation with Biogenic Zingiber officinale Capped Silver-Nanobiotic, Chlorhexidine Diacetate and Lyophilized Miswak. Molecules 2022, 27, 528. [Google Scholar] [CrossRef]

| Thymus vulgaris Extract | TVE-CuNPs | ||
|---|---|---|---|
| Peak (cm−1) | Functional Groups | Peak (cm−1) | Functional Groups |
| 3429 | Amine group (N–H) and the hydroxyl group (O–H) | 3402 | Amine group (N–H) and the hydroxyl group (O–H) |
| 2920 | C–H in methyl and alkanes | 2927 | C–H in methyl and alkanes |
| 1624 | C=O stretching of amide in carbonyl stretch in proteins/enzymes | 1631 | C=O stretching of amide in carbonyl stretch in proteins/enzymes |
| 1060 | C–O of proteins | 1094 | C–O of proteins |
| Bacteria | Samples (Groups) | Inhibition Zone (mm) | ANOVA F Value | ANOVA P Value | Tukey’s Post Hoc | ||
|---|---|---|---|---|---|---|---|
| 1 Day | 2 Weeks | 1 Month | |||||
| S. aureus | a. Group 1 | NA | NA | NA | NA | NA | NA |
| b. Group 2 | 14 ± 1.62 | 13 ± 1.52 | 11 ± 0.57 | 7.62 | 0.02 | 1 day > 2 week and 1 month | |
| c. Group 3 | 20 ± 1.53 | 17 ± 1.21 | 15 ± 1.35 | 11.81 | 0.01 | 1 day > 2 week and 1 month | |
| d. Group 4 | 29 ± 1.11 | 22 ± 1.27 | 19 ± 1.56 | 13.43 | 0.001 | 1 day > 2 week and 1 month | |
| e. Group 5 | 24 ± 1.41 | 19 ± 0.57 | 16 ± 1.00 | 8.9 | 0.01 | 1 day > 2 week and 1 month | |
| f. Group 6 | 30 ± 1.71 | 23 ± 1.52 | 18 ± 1.15 | 14.30 | 0.001 | 1 day > 2 week and 1 month | |
| ANOVA F Value | 16.71 | 14.65 | 17.35 | ||||
| ANOVA p-Value | 0.0001 | 0.001 | 0.001 | ||||
| Tukey’s post Hoc | f > d > e > c > b | f > d > e > c > b | f > d > e > c > b | ||||
| S. mutans | a. Group 1 | NA | NA | NA | NA | NA | NA |
| b. Group 2 | 18 ± 1.93 | 16 ± 1.67 | 12 ± 1.58 | 9.62 | 0.03 | 1 day > 2 week and 1 month | |
| c. Group 3 | 19 ± 1.26 | 16 ± 1.31 | 13 ± 1.55 | 11.9 | 0.01 | 1 day > 2 week and 1 month | |
| d. Group 4 | 26 ± 1.34 | 21 ± 1.88 | 18 ± 1.17 | 16.30 | 0.001 | 1 day > 2 week and 1 month | |
| e. Group 5 | 20 ± 1.65 | 18 ± 1.53 | 14 ± 1.66 | 11.9 | 0.01 | 1 day > 2 week and 1 month | |
| f. Group 6 | 27 ± 1.35 | 23 ± 1.93 | 17 ± 1.69 | 16.30 | 0.001 | 1 day > 2 week and 1 month | |
| ANOVA F Value | 16.26 | 15.52 | 14.36 | ||||
| ANOVA p-Value | 0.001 | 0.001 | 0.001 | ||||
| Tukey’s post Hoc | f > d > e > c > b | f > d > e > c > b | f > d > e > c > b | ||||
| Tested Groups | n | Mean ± SD | ANOVA F Value | ANOVA p Value |
|---|---|---|---|---|
| Group 1 | 8 | 41.2 ± 3.4 | 2.74 | 0.165 |
| Group 2 | 8 | 42.8 ± 2.8 | ||
| Group 3 | 8 | 44.2 ± 3.8 | ||
| Group 4 | 8 | 43.9 ± 3.7 | ||
| Group 5 | 8 | 45.9 ± 4.1 | ||
| Group 6 | 8 | 45.0 ± 4.5 |
| Materials | Concentration | Bacteria | Reference |
|---|---|---|---|
|
|
|
|
|
|
|
|
|
|
|
|
|
|
|
|
|
|
|
|
Publisher’s Note: MDPI stays neutral with regard to jurisdictional claims in published maps and institutional affiliations. |
© 2022 by the authors. Licensee MDPI, Basel, Switzerland. This article is an open access article distributed under the terms and conditions of the Creative Commons Attribution (CC BY) license (https://creativecommons.org/licenses/by/4.0/).
Share and Cite
Ashour, A.A.; Felemban, M.F.; Felemban, N.H.; Enan, E.T.; Basha, S.; Hassan, M.M.; Gad El-Rab, S.M.F. Comparison and Advanced Antimicrobial Strategies of Silver and Copper Nanodrug-Loaded Glass Ionomer Cement against Dental Caries Microbes. Antibiotics 2022, 11, 756. https://doi.org/10.3390/antibiotics11060756
Ashour AA, Felemban MF, Felemban NH, Enan ET, Basha S, Hassan MM, Gad El-Rab SMF. Comparison and Advanced Antimicrobial Strategies of Silver and Copper Nanodrug-Loaded Glass Ionomer Cement against Dental Caries Microbes. Antibiotics. 2022; 11(6):756. https://doi.org/10.3390/antibiotics11060756
Chicago/Turabian StyleAshour, Amal Adnan, Mohammed Fareed Felemban, Nayef H. Felemban, Enas T. Enan, Sakeenabi Basha, Mohamed M. Hassan, and Sanaa M. F. Gad El-Rab. 2022. "Comparison and Advanced Antimicrobial Strategies of Silver and Copper Nanodrug-Loaded Glass Ionomer Cement against Dental Caries Microbes" Antibiotics 11, no. 6: 756. https://doi.org/10.3390/antibiotics11060756
APA StyleAshour, A. A., Felemban, M. F., Felemban, N. H., Enan, E. T., Basha, S., Hassan, M. M., & Gad El-Rab, S. M. F. (2022). Comparison and Advanced Antimicrobial Strategies of Silver and Copper Nanodrug-Loaded Glass Ionomer Cement against Dental Caries Microbes. Antibiotics, 11(6), 756. https://doi.org/10.3390/antibiotics11060756







